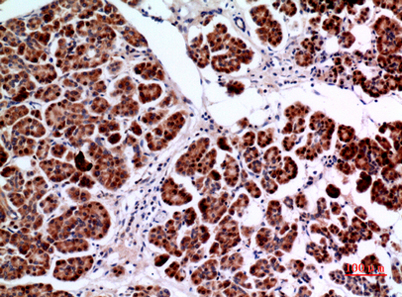

Amphiphysin II rabbit pAb
 One-click to copy product information
One-click to copy product information$148.00/50µL $248.00/100µL
| 50 µL | $148.00 |
| 100 µL | $248.00 |
Overview
| Product name: | Amphiphysin II rabbit pAb |
| Reactivity: | Mouse;Rat |
| Alternative Names: | BIN1; AMPHL; Myc box-dependent-interacting protein 1; Amphiphysin II; Amphiphysin-like protein; Box-dependent myc-interacting protein 1; Bridging integrator 1 |
| Source: | Rabbit |
| Dilutions: | Western Blot: 1/500 - 1/2000. IHC-p: 1/100-1/300. ELISA: 1/20000. Not yet tested in other applications. |
| Immunogen: | Synthesized peptide derived from the C-terminal region of human Amphiphysin II. |
| Storage: | -20°C/1 year |
| Clonality: | Polyclonal |
| Isotype: | IgG |
| Concentration: | 1 mg/ml |
| Observed Band: | 64kD |
| GeneID: | 274 |
| Human Swiss-Prot No: | O00499 |
| Cellular localization: | [Isoform BIN1]: Nucleus . Cytoplasm . Endosome . Cell membrane, sarcolemma, T-tubule .; [Isoform IIA]: Cytoplasm . |
| Background: | This gene encodes several isoforms of a nucleocytoplasmic adaptor protein, one of which was initially identified as a MYC-interacting protein with features of a tumor suppressor. Isoforms that are expressed in the central nervous system may be involved in synaptic vesicle endocytosis and may interact with dynamin, synaptojanin, endophilin, and clathrin. Isoforms that are expressed in muscle and ubiquitously expressed isoforms localize to the cytoplasm and nucleus and activate a caspase-independent apoptotic process. Studies in mouse suggest that this gene plays an important role in cardiac muscle development. Alternate splicing of the gene results in several transcript variants encoding different isoforms. Aberrant splice variants expressed in tumor cell lines have also been described. [provided by RefSeq, Mar 2016], |
-
 Western Blot analysis of mouse brain cells using Amphiphysin II Polyclonal Antibody. Secondary antibody(catalog#:RS0002) was diluted at 1:20000
Western Blot analysis of mouse brain cells using Amphiphysin II Polyclonal Antibody. Secondary antibody(catalog#:RS0002) was diluted at 1:20000 -
Immunohistochemical analysis of paraffin-embedded human-pancreas, antibody was diluted at 1:100
Immunohistochemical analysis of paraffin-embedded human-pancreas, antibody was diluted at 1:100 -
 Immunohistochemical analysis of paraffin-embedded human-pancreas, antibody was diluted at 1:100
Immunohistochemical analysis of paraffin-embedded human-pancreas, antibody was diluted at 1:100 -
 Immunohistochemical analysis of paraffin-embedded mouse-muscle, antibody was diluted at 1:100
Immunohistochemical analysis of paraffin-embedded mouse-muscle, antibody was diluted at 1:100

 Manual
Manual